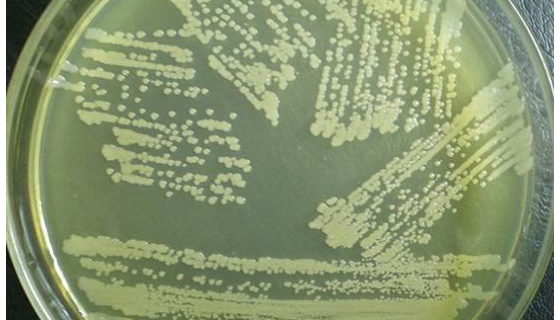
Saccharopolyspora Pogona的注意事项有哪些？
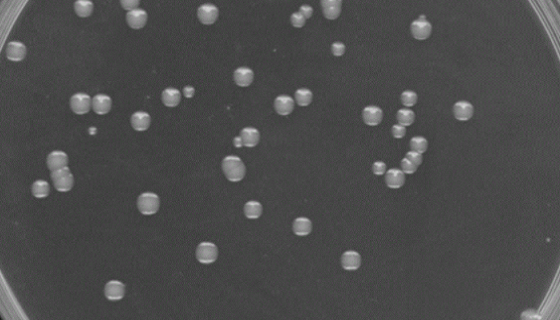
鞘氨醇单胞菌属菌株及其在水处理中的应用！
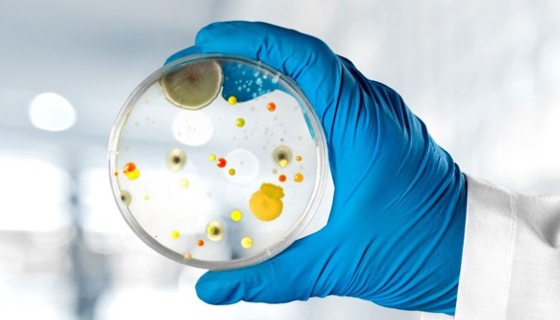
微生物限度检查中常见的问题分析及操作方法！

甲烷杆菌的发现过程与培养条件及主要应用!
甲烷杆菌(Methanobacteriaceae)是细菌的一...
Saccharopolyspora Pogona的注意事项有哪些?
糖多孢菌是Saccharopolyspora属的微生物,原产...
鞘氨醇单胞菌属菌株及其在水处理中的应用!
鞘氨醇单胞菌属是一类丰富的新型微生物资源,可用于芳香化合物的...
微生物限度检查中常见的问题分析及操作方法!
微生物限度检查中常见的问题分析及操作方法!

小鼠周细胞MBVP的实验室分离方法与质量检测!
小鼠周细胞是血管周细胞,与毛细血管内皮和其它小血管有紧密联系...

奇异变形杆菌的生化鉴定及检测方法的研究进展!
奇异变形杆菌(Proteus mirabilis)是一种两端...

贾第虫病的鉴别诊断与检查方法及治疗与预防!
蓝氏贾第鞭毛虫病现通称贾第虫病,是由蓝氏贾第鞭毛虫寄生在人体...

表皮葡萄球菌的致病性与免疫性及临床表现!
表皮葡萄球菌是滋生于生物体表皮上的一种细菌。在人体的皮肤,阴...

褐色高温单孢菌的性质与分类及培养方法!
褐色高温单孢菌只在气丝上产生单个孢子。由于孢子柄一再分枝,每...